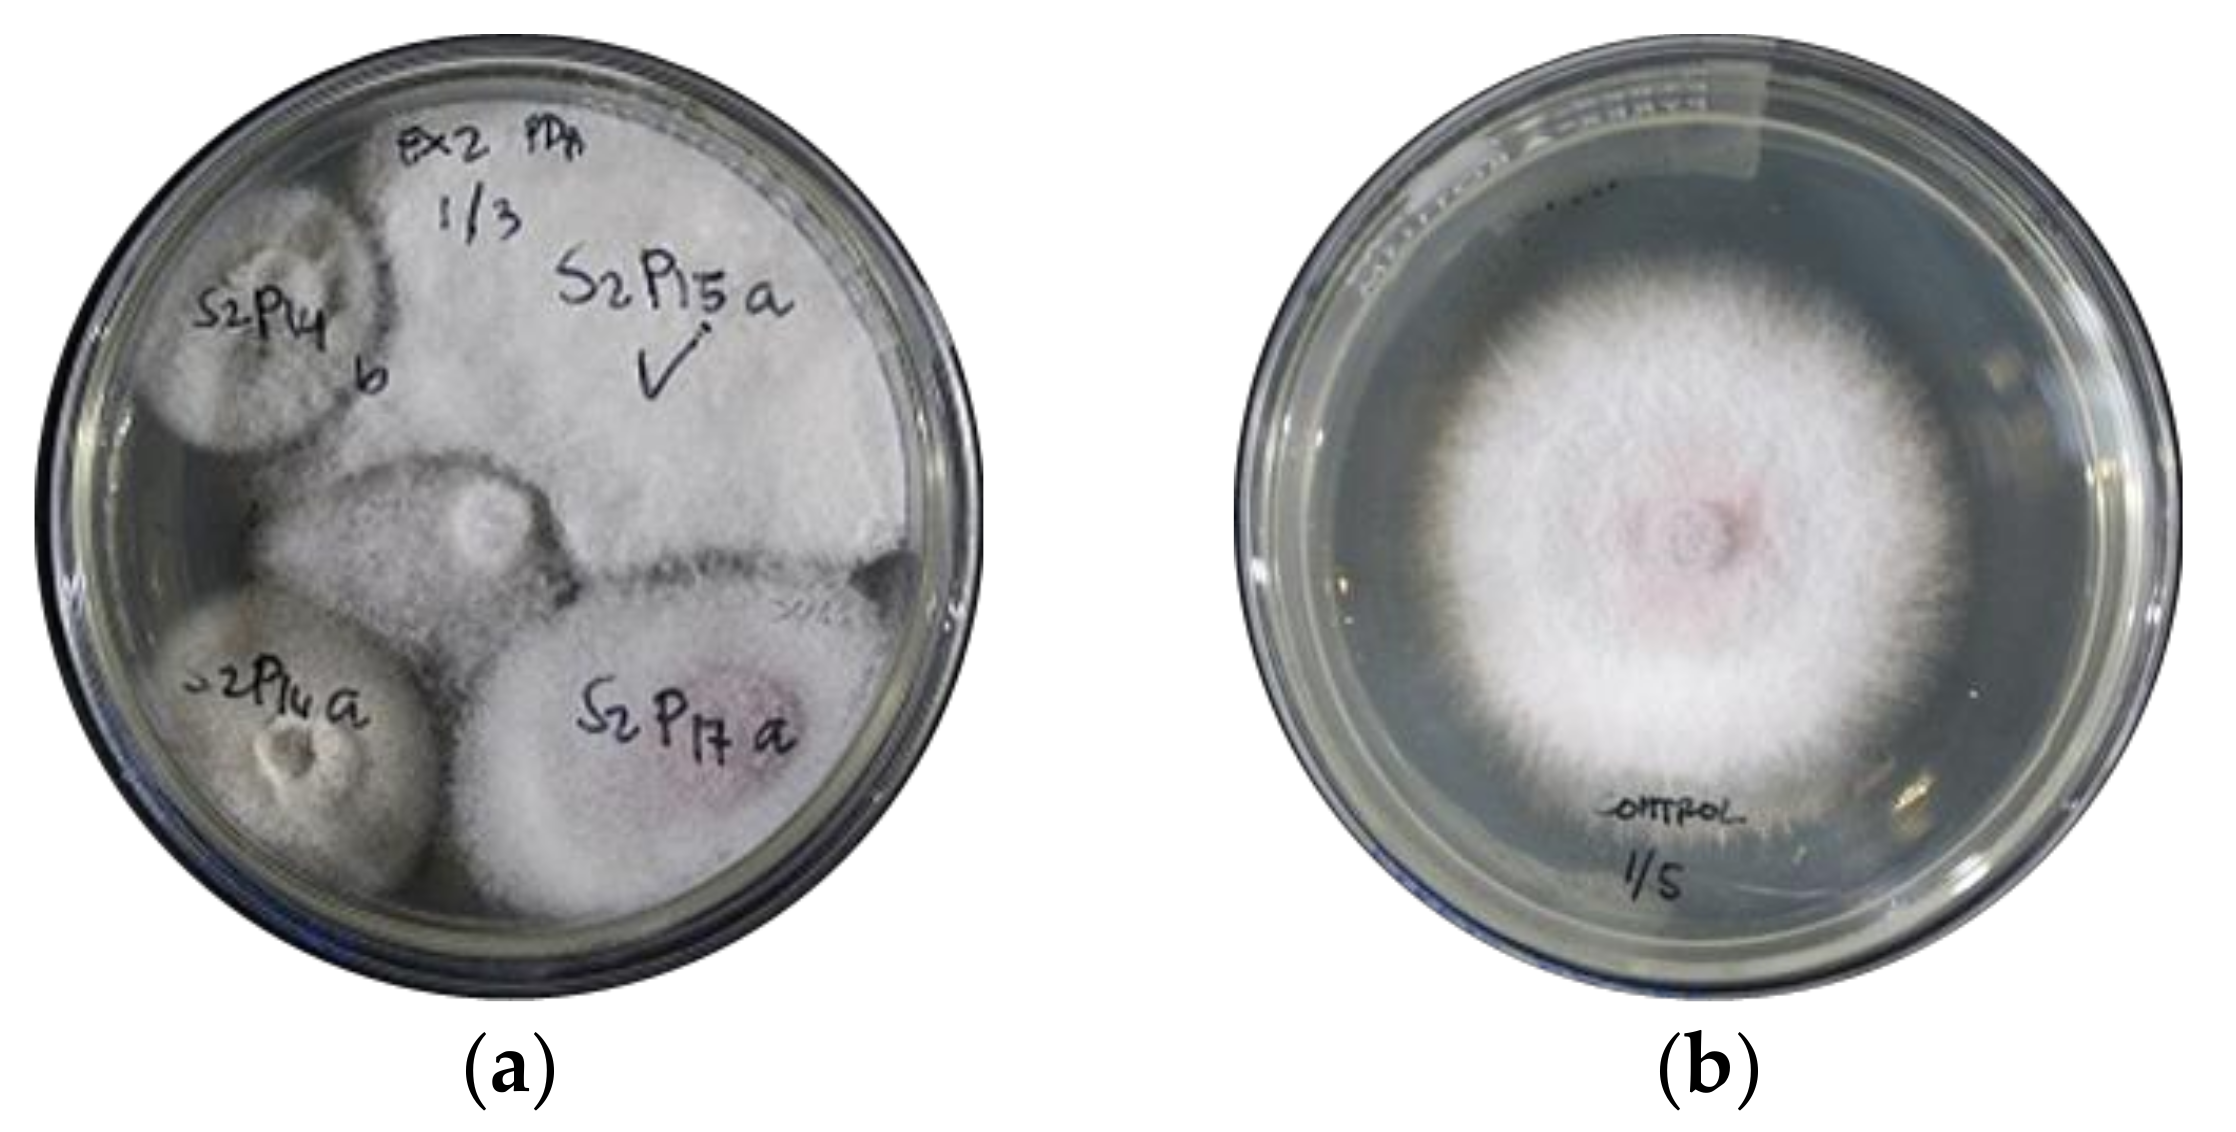
Jof 07 00224 g002
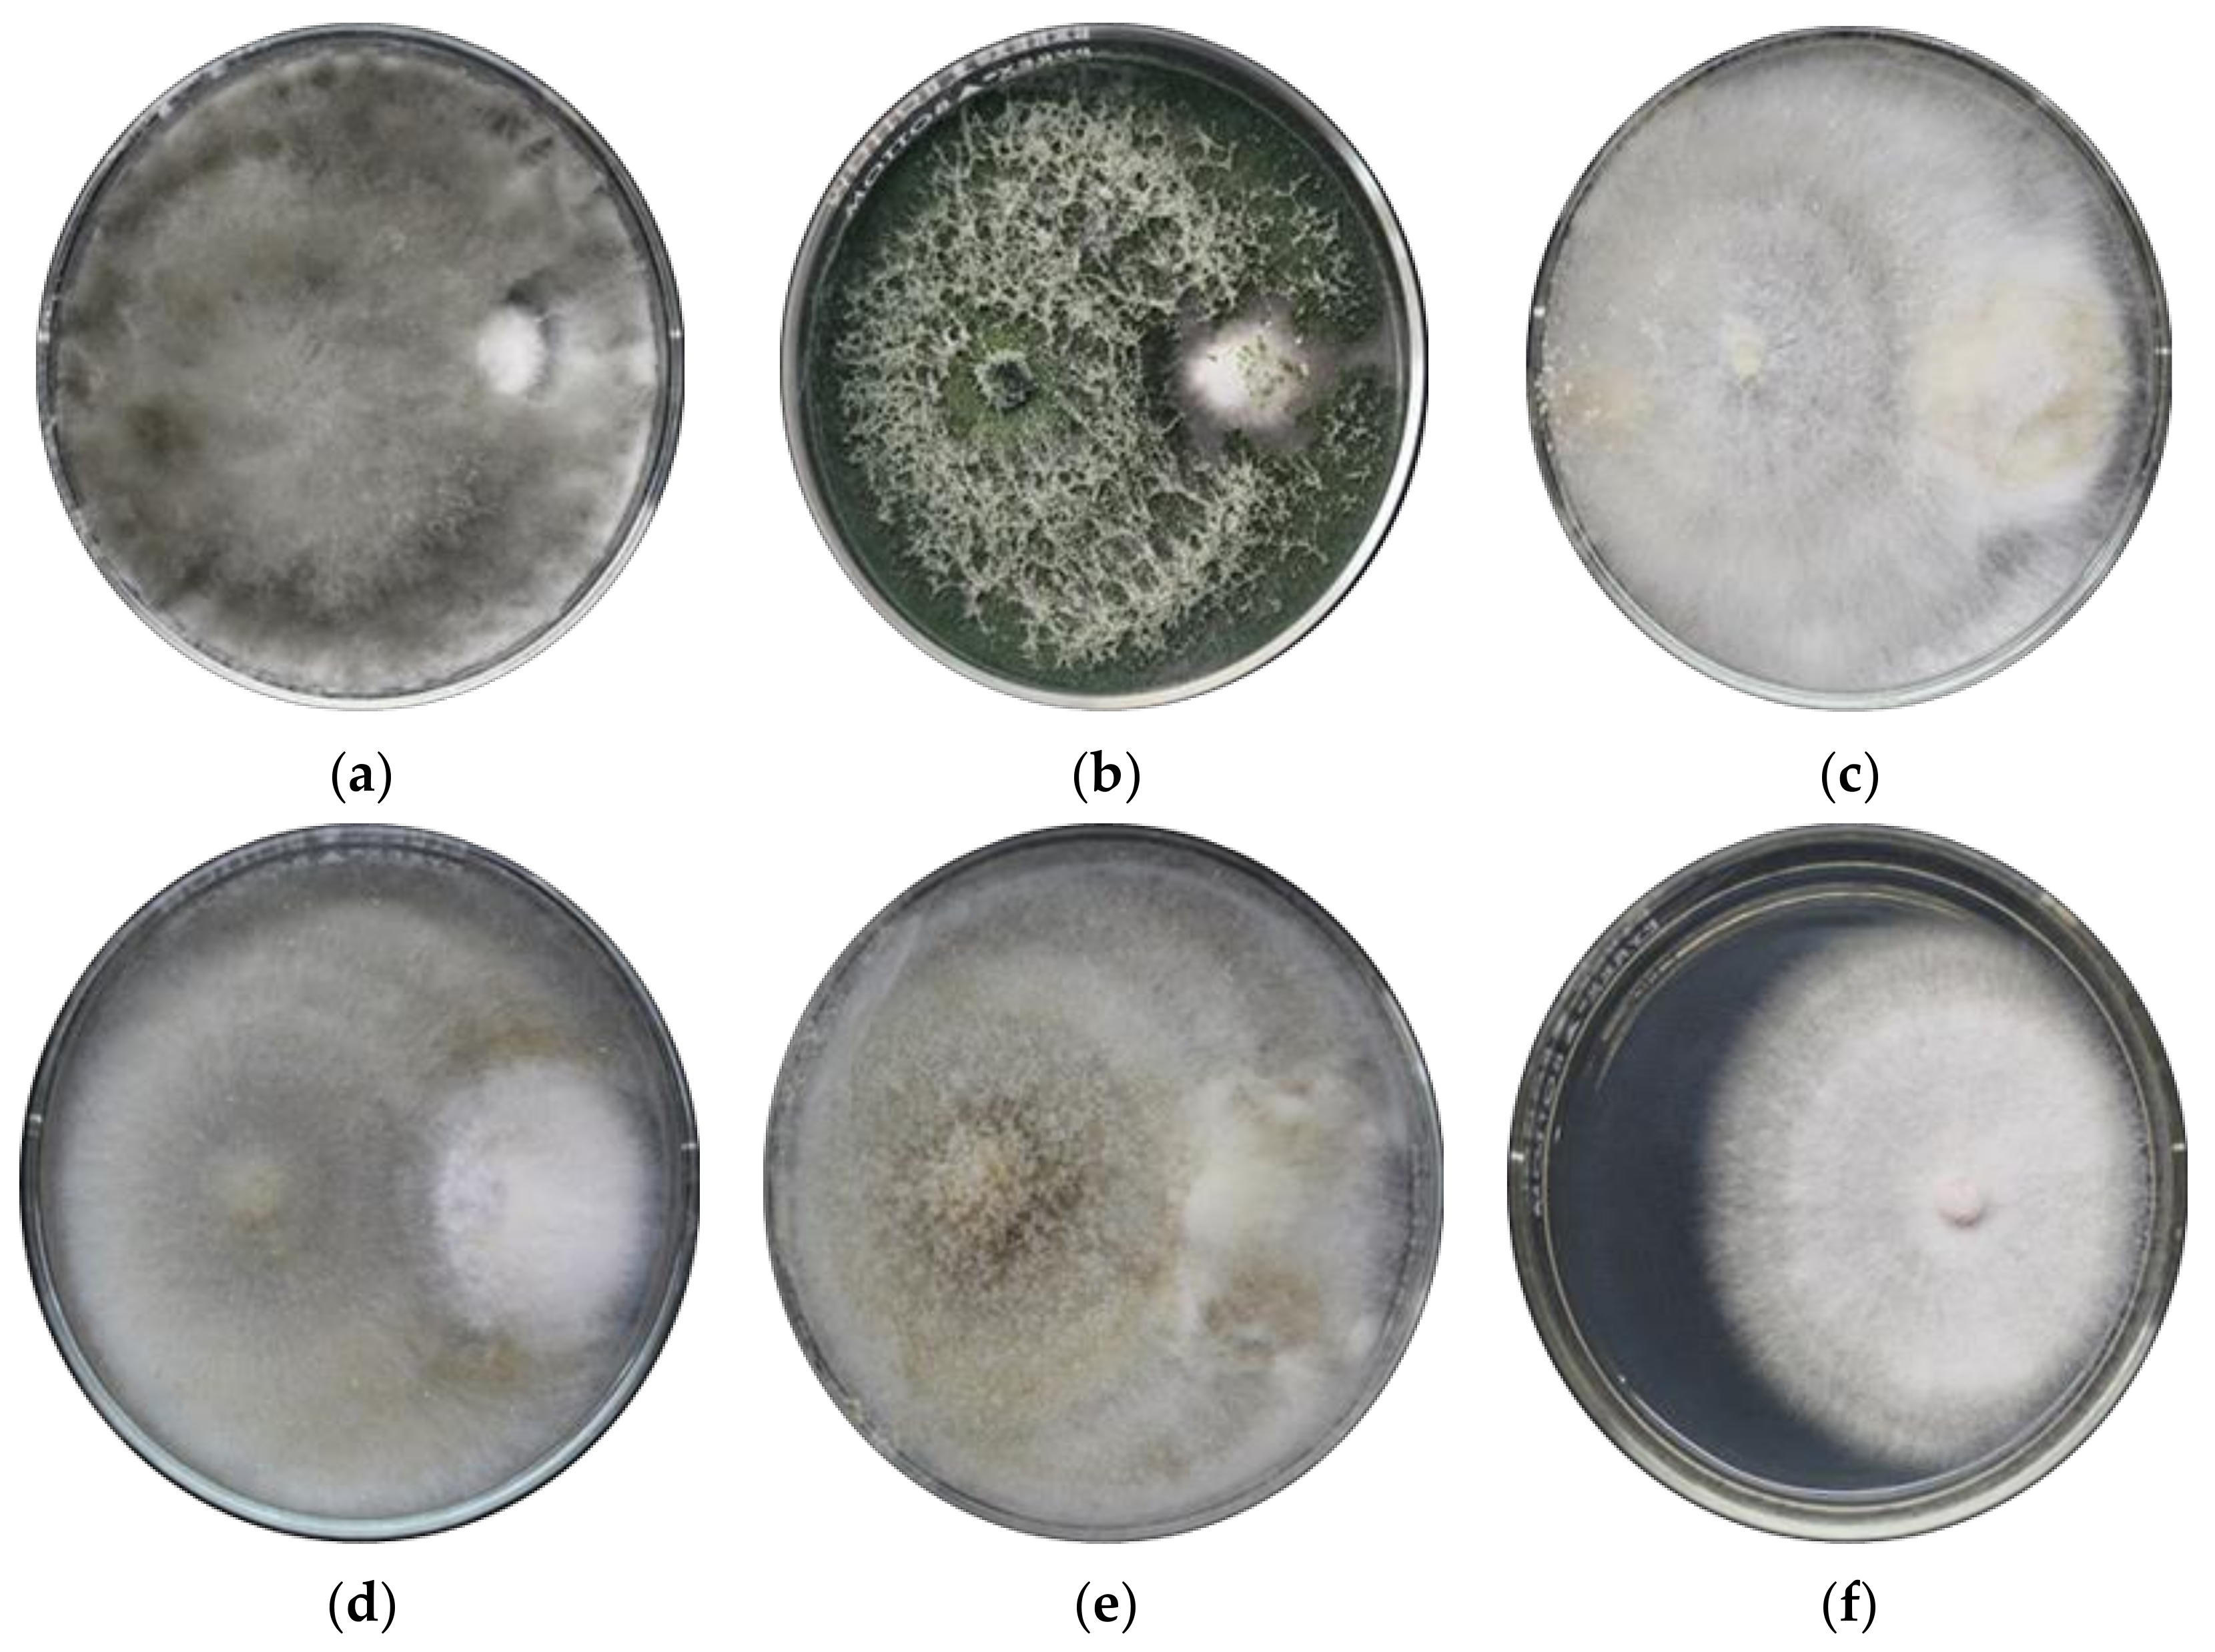
Jof 07 00224 g003

Weed-Associated Fungal Endophytes as Biocontrol Agents of Fusarium oxysporum f. sp. cubense TR4 in Cavendish Banana
Abstract
1. Introduction
2. Materials and Methods
2.1. Endophytic Fungi Source Collection and Isolation
2.2. Cavendish Banana Plantlets
2.3. Foc TR4 from Cavendish Banana
2.4. Identification of Fungal Endophytes
2.4.1. DNA-Based Identification
2.4.2. Based on Morphological Characteristics
2.5. In Vitro Assay on Antagonistic Activity of Fungal Endophytes
2.6. Pathogenicity Test of Fungal Endophytes to Cavendish Banana
2.7. Greenhouse Test of Fungal Endophytes vs. Foc TR4
2.8. Statistical Analysis
3. Results and Discussion
3.1. Fungal Endophytes from Weeds
3.2. Antagonism of Fungal Endophytes Against Foc TR4
3.2.1. In Vitro Assays
3.2.2. Pathogenicity of Fungal Endophytes to Cavendish Banana
3.2.3. Screenhouse Test of Fungal Endophytes vs. Foc TR4
3.3. DNA-Based Identification of Fungal Endophytes
Supplementary Materials
Author Contributions
Funding
Institutional Review Board Statement
Informed Consent Statement
Data Availability Statement
Acknowledgments
Conflicts of Interest
References
- FAO Banana Market Review for 2018. 2009. Available online: http://www.fao.org/publications/card/en/c/CA5626EN (accessed on 10 September 2019).
- Molina, A.; Fabregar, E.; Sinohin, V.G.; Herradura, L.; Fourie, G.; Viljoen, A. Confirmation of Tropical race 4 of Fusarium oxysporum f. sp. cubense, Infecting Cavendish Bananas in the Philippines. In APS Abstract of Presentation in 2008 APS Centennial Meeting. 2008. Available online: https://www.apsnet.org/meetings/Documents/2008_Meeting_Abstracts/a08ma559.htm (accessed on 10 August 2019).
- Pérez-Vicente, L. Fusarium wilt (Panama disease) of Bananas: An Updating Review of the Current Knowledge on the Disease and its Causal a gent. Proceeding of the Memorias de XV Reunion Internacional de ACORBAT, Oaxaca, Mexico, 26 September–1 October 2004; pp. 1–14. [Google Scholar]
- Bubici, G.; Kaushal, M.; Prigigallo, M.I.; Gómez-Lama Cabanás, C.; Mercado-Blanco, J. Biological Control Agents Against Fusarium Wilt of Banana. Front. Microbiol. 2019, 10, 616. [Google Scholar] [CrossRef]
- Köberl, M.; Dita, M.; Martinuz, A.; Staver, C.; Berg, G. Members of gamma proteo bacteria as indicator species of healthy banana plants on Fusarium wilt-infested fields in Central America. Sci. Rep. 2017, 7, 45318. [Google Scholar] [CrossRef] [PubMed]
- Jaber, L.R.; Alananbeh, K.M. Fungal entomopathogens as endophytes reduce several species of Fusarium causing crown and root rot in sweet pepper (Capsicum annuum L.). Biol. Control 2018, 126, 117–126. [Google Scholar] [CrossRef]
- Van Wees, S.C.; Van der Ent, S.; Pieterse, C.M. Plant immune responses triggered by beneficial microbes. Curr. Opin. Plant Biol. 2008, 11, 443–448. [Google Scholar] [CrossRef]
- Massenssini, A.; Bonduki, V.; Melo, C. Soil microorganisms and their role in the interactions between weeds and crops. Planta Daninha 2014, 32, 873–884. [Google Scholar] [CrossRef]
- Martinez-klimova, E.; Rodriguez-Peňa, K.; Sanchez, S. Endophytes as sources of antibiotics. Biochem. Pharmacol. 2017, 134, 1–17. [Google Scholar] [CrossRef] [PubMed]
- Li, X.; Wang, J.; Zhang, S.; Wang, H.; Li, X.; Li, X.; Zhang, H. Distribution of fungal endophytes in roots of Stipa krylovii across six vegetation types in grassland of northern China. Fungal. Ecol. 2018, 31, 47–53. [Google Scholar] [CrossRef]
- Van den Berg, N.; Bergr, D.; Hein, I.; Birch, P.R.; Wingfield, M.J.; Viljoen, A. Tolerance in banana to Fusarium wilt is associated with up-regulation of cell wall-strengthening genes in the roots. Mol. Plant Pathol. 2007, 8, 333–341. [Google Scholar] [CrossRef] [PubMed]
- Doyle, J. DNA Protocols for Plants. In Molecular Techniques in Taxonomy; NATO ASI Series (Series H: Cell, Biology); Hewitt, G.M., Johnston, A.W.B., Young, J.P.W., Eds.; Springer: Berlin/Heidelberg, Germany, 1991; Volume 57, pp. 283–293. [Google Scholar]
- Dita, M.A.; Waalwijk, C.; Buddenhaguen, I.W.; Souza, M.T.; Kema, G.H.J. A molecular diagnosis for tropical race 4 of the banana Fusarium wilt pathogen. Plant Pathol. 2010, 59, 348–357. [Google Scholar] [CrossRef]
- White, T.J.; Bruns, T.; Lee, S.; Taylor, J. Amplification and Direct Sequencing of Fungal Ribosomal rNA Genes for Phylogenetics. In PCR Protocols. A Guide to Methods and Applications; Innis, M.A., Gelfand, D.H., Sninsky, J.J., White, T.J., Eds.; Academic Press: San Diego, CA, USA, 1990; pp. 315–322. [Google Scholar]
- Watanabe, T. Pictorial Atlas of Soil and Seed Fungi: Morphologies of Cultured Fungi and Key to Species, 2nd ed.; CRC Press: Washington, DC, USA, 2002. [Google Scholar]
- Sonawane, A.; Mahjan, M.; Renake, S. Antifungal activity of a fungal isolate against pomegranate wilt pathogen Fusarium. Int. J. Curr. Microbiol. Appl. Sci. 2015, 2, 48–57. [Google Scholar]
- Soytong, K. Identification of Species of Chaetomium in the Philippines and Screening for Their Biocontrol Properties against Seed Borne Fungi of Rice. Ph.D. Thesis, Department Plant Pathology-University of the Philippines, Los Baños/Laguna, Philippines, 1988. [Google Scholar]
- Puig, C.G.; Cumagun, C.J.R. Rainforest fungal endophytes for the bio-enhancement of banana toward Fusarium oxysporum f.sp cubense Tropical race 4. Arch. Phytopathol. Plant Prot. 2019, 52, 776–794. [Google Scholar] [CrossRef]
- Dita, M.A.; Vicente, L.P.; Martinez, E. Inoculation of Fusarium oxysporum f. sp. Cubense Causal Agent of Fusarum wilt of Banana. In Prevention and Diagnostic of Fusarium wilt (Panama disease) of Banana Caused by Fusarium oxysporum f. sp. Cubense Tropical Race 4 (TR4). Technical Manual Prepared for the Regional Training Workshop on the Diagnosis of Fusarium Wilt; Perez-Vicente, L., Dita, M.A., Martinez-de la Parte, E., Eds.; FAO Regional Office of the Caribbean and CARDI (Caribbean Agricultural Research and Development Institute): St. Augustine, Trinidad and Tobago, 2014; p. 57. [Google Scholar]
- Carlier, J.; De Waele, D.; Escalant, J.V. Global evaluation of Musa germplasm for resistance to Fusarium wilt, Mycosphaerella leaf spot diseases and nematodes. In INIBAP Technical Guidelines 7; Vézina, A., Picq, C., Eds.; The International Network for the Improvement of Banana and Plantain Arceaux 49 Press: Montpellier, France, 2003; p. 12. [Google Scholar]
- Schoch, C.L.; Seifert, K.A.; Huhndorf, S.; Robert, V.; Spouge, J.L.; Levesque, C.A.; Chen, W. Nuclear ribosomal internal transcribed spacer (ITS) region as a universal barcode marker for fungi. Proc. Natl. Acad. Sci. USA 2012, 109, 6241–6246. [Google Scholar] [CrossRef] [PubMed]
- Castillo, A.G.; Puig, C.G.; Cumagun, C.J.R. Non-synergistic effect of Trichoderma harzianum and Glomus spp. in reducing infection of Fusarium wilt in banana. Pathogens 2019, 8, 43. [Google Scholar] [CrossRef]
- Strobel, G.A. The emergence of endophytic microbes and their biological promise. J. Fungi 2018, 4, 57. [Google Scholar] [CrossRef]
- Hirsch, G.; Braun, U. Communities of Parasitic Microfungi. In Handbook of Vegetation Science; Winterhoff, W., Ed.; Kluwer Academic Publishers: Dordrecht, The Netherlands, 1992; pp. 225–250. [Google Scholar]
- Krings, M.; Taylor, T.N.; Hass, H.; Kerp, H.; Dotzler, N.; Hernsen, E.J. Fungal endophytes in a 400-million-year-old land plant: Infection pathways, spatial distribution and host responses. N. Phytol. 2007, 174, 648–657. [Google Scholar] [CrossRef]
- Strobel, G.; Daisy, B.; Castillo, U.; Harper, J. Natural products from endophytic microorganisms. J. Nat. Prod. 2004, 67, 257–268. [Google Scholar] [CrossRef] [PubMed]
- Davey, M.L.; Currah, R.S. Interactions between mosses (Bryophyta) and fungi. Can. J. Bot. 2006, 84, 1509–1519. [Google Scholar] [CrossRef]
- Swatzell, L.J.; Powell, M.J.; Kiss, J.Z. The relationship of endophytic fungi to the gametophyte of the fern Schizaea pusilla. Int. J. Plant Sci. 1996, 157, 53–62. [Google Scholar] [CrossRef] [PubMed][Green Version]
- Su, Y.Y.; Guo, L.D.; Hyde, K.D. Response of endophytic fungi of Stipa grandis to experimental plant function group removal in Inner Mongolia steppe, China. Fungal Divers. 2010, 43, 93–101. [Google Scholar] [CrossRef]
- Petrini, O.; Stone, J.; Carroll, F.E. Endophytic fungi in evergreen shrubs in western Oregon: A preliminary study. Can. J. Bot. 1982, 60, 789–796. [Google Scholar] [CrossRef]
- Mohamed, R.; Jong, P.L.; Zali, M.S. Fungal diversity in wounded stems of Aquilaria malaccensis. Fungal Divers. 2010, 43, 67–74. [Google Scholar] [CrossRef]
- Smith, R.G. A succession-energy framework for reducing non-target impacts of annual crop production. Agric. Syst. 2015, 133, 14–21. [Google Scholar] [CrossRef]
- Belgrove, A.; Steinberg, C.; Viljoen, A. Evaluation of nonpathogenic Fusarium oxysporum and Pseudomonas fluorescens for Panama disease control. Plant Dis. 2011, 95, 951–959. [Google Scholar] [CrossRef]
- Thangavelu, R.; Jayanthi, A. RFLP analysis of rDNA-ITS regions of native non-pathogenic Fusarium oxysporum isolates and their field evaluation for the suppression of Fusarium wilt disease of banana. Australas. Plant Path. 2009, 38, 13–21. [Google Scholar] [CrossRef]
- Forsyth, L.M.; Smith, L.J.; Aitken, E.A. Identification and characterization of non-pathogenic Fusarium oxysporum capable of increasing and decreasing Fusarium wilt severity. Mycol. Res. 2006, 110, 929–935. [Google Scholar] [CrossRef] [PubMed]
- Ma, L.J.; Van der Does, H.C.; Borkovich, K.A.; Coleman, J.J.; Daboussi, M.J.; Pietro, A.; Dufresne, M.; Freitag, M.; Grabherr, M.; Henrissat, B.; et al. Comparative genomics reveals mobile pathogenicity chromosomes in Fusarium. Nature 2010, 464, 367–373. [Google Scholar] [CrossRef]
- Pandi, M.; Rangarajulu, S.K.; Choi, Y.K.; Kim, H.J.; Muthumary, J. Isolation and detection of taxol, an anticancer drug product of Lasiodiplodia theobromae, an endophytic fungus of the medicinal plant Morinda citrifolia. Afr. J. Biotechnol. 2011, 10, 1428–1435. [Google Scholar]
- Wani, M.C.; Taylor, H.L.; Wall, M.E.; Coggon, P.; Mcphail, A.T. Plant antitumor agents VI. The isolation and structure of taxol, a novel antileukemic and antitumor agent from Taxus brevifolia. J. Am. Chem. Soc. 1971, 93, 2325–2327. [Google Scholar] [CrossRef]
- Rowinsky, E.K.; Cazenave, L.A.; Donehower, R.C. Taxol: A novel investigational antimicrotubule agent. J. Natl. Cancer Inst. 1990, 82, 1247–1259. [Google Scholar] [CrossRef]
- Croom, E.M. Taxus for Taxol and Toxoids. In Taxol- Science and Applications; Suffness, M., Ed.; CRC Press: Boca Raton, FL, USA, 1995; pp. 37–70. [Google Scholar]
- El-hawary, S.S.; Sayed, A.M.; Rateb, M.E.; Bakeer, W.; Abouzid, S.F.; Mohammed, R. Secondary metabolites from fungal endophytes of Solanum nigrum. Nat. Prod. Res. 2017, 31, 2568–2571. [Google Scholar] [CrossRef]
- Eng, F.; Haroth, S.; Feussner, K.; Meldau, D.; Rekhter, D.; Ischebeck, T.; Brodhun, F.; Feussner, I. Optimized jasmonic acid production by Lasiodiplodia theobromae reveals formation of valuable plant secondary metabolites. PLoS ONE 2016, 11, e0167627. [Google Scholar] [CrossRef] [PubMed]
- Wasternack, C.; Hause, B. Jasmonates: Biosynthesis, perception, signal transduction and action in plant stress response, growth and development. Ann. Bot. 2013, 111, 1021–1058. [Google Scholar] [CrossRef]
- Thangavelu, R.; Gopi, M. Field suppression of Fusarium wilt disease in banana by the combined application of native endophytic and rhizospheric bacterial isolates possessing multiple functions. Phytopathol. Mediterr. 2015, 54, 241–252. [Google Scholar]
- Smith, S.E.; Read, D.J. Mycorrhizal Symbiosis, 2nd ed.; Academic Press: San Diego, CA, USA, 1997; 605p. [Google Scholar]
- Burpee, L.; Goulty, G. Suppression of brown patch disease of creeping bent grass by isolates of nonpathogenic Rhizoctonia spp. Phythopathology 1984, 74, 692–694. [Google Scholar] [CrossRef]
- Villajuan-Abgona, R.; Kageyama, K.; Hyakurnachi, M. Biocontrol of Rhizoctonia damping-off of cucumber by non-pathogenic binucleate Rhizoctonia. Eur. J. Plant Pathol. 1996, 102, 227–235. [Google Scholar] [CrossRef]
- Jabaji-hare, S.; Neate, S.M. Nonpathogenic binucleate Rhizoctonia spp. and benzothiadiazole protect cotton seedlings against Rhizoctonia damping-off and Alternaria leaf spot in cotton. Phytopathology 2005, 95, 1030–1036. [Google Scholar] [CrossRef] [PubMed]
- Khan, F.U.; Nelson, B.D.; Helms, T.C. Greenhouse evaluation of binucleate Rhizoctonia for control of R. solani in soybean. Plant Dis. 2005, 89, 373–379. [Google Scholar] [CrossRef]
- Mosquera-espinosa, A.T.; Bayman, P.; Prado, G.A.; Gomez-Carabali, A.; Otero, J.T. The double life of Ceratobasidium: Orchid mycorrhizal fungi and their potential for biocontrol of Rhizoctonia solani sheath blight of rice. Mycologia 2012, 105, 141–150. [Google Scholar] [CrossRef]
- Ploetz, R.C. Fusarium wilt of banana. Phytopathology 2015, 105, 1512–1521. [Google Scholar] [CrossRef]

| Fungal Endophytes | Disease Incidence (%) | |||
|---|---|---|---|---|
| Grand Naine | GCTCV 218 | Mean | STDEV | |
| Control | 100.00 | 100.00 | 100.00 b | 0.0 |
| Lasiodiplodia theobromae TDC029 | 92.16 | 82.36 | 87.26 a | 12.0 |
| Trichoderma asperellum TDC075 | 98.04 | 72.74 | 85.39 a | 15.9 |
| Ceratobasidum sp. TDC037 | 98.04 | 84.31 | 91.18 ab | 12.1 |
| Ceratobasidum sp. TDC241 | 98.04 | 84.32 | 91.18 ab | 8.9 |
| Ceratobasidum sp. TDC474 | 98.04 | 78.43 | 88.23 a | 11.7 |
| MEAN * | 97.39 b | 83.69 a | ||
| STDEV | 4.1 | 12.4 | ||
| Fungal Endophytes | Leaf Yellowing (%) | |||
|---|---|---|---|---|
| Grand Naine | GCTCV 218 | Mean | STDEV | |
| Control | 44.12 | 29.41 | 36.77 b | 8.4 |
| Lasiodiplodia theobromae TDC 029 | 36.27 | 21.57 | 28.92 ab | 9.8 |
| Trichoderma asperellum TDC 075 | 38.24 | 23.04 | 30.64 ab | 9.9 |
| Ceratobasidum sp. TDC 037 | 30.39 | 23.04 | 26.72 a | 5.3 |
| Ceratobasidum sp. TDC 241 | 32.84 | 23.04 | 27.94 ab | 8.6 |
| Ceratobasidum sp. TDC 474 | 36.77 | 19.12 | 27.94 ab | 10.1 |
| MEAN * | 36.44 b | 23.20 a | ||
| STDEV | 6.4 | 5.2 | ||
| Fungal Endophytes | Rhizome Discoloration (%) | ||||
|---|---|---|---|---|---|
| Grand Naine | GCTCV 218 | Mean | STDEV | ||
| Control | 56.08 | 33.33 | 44.71 b | 13.8 | |
| Lasiodiplodia theobromae TDC029 | 41.96 | 21.18 | 31.57 a | 12.6 | |
| Trichoderma asperellum TDC075 | 47.06 | 22.36 | 34.71 a | 13.6 | |
| Ceratobasidum sp. TDC037 | 41.18 | 24.32 | 32.75 a | 10.0 | |
| Ceratobasidum sp. TDC241 | 41.18 | 22.35 | 31.77 a | 11.9 | |
| Ceratobasidum sp. TDC474 | 43.53 | 22.75 | 33.14 a | 12.0 | |
| MEAN * | 45.17 b | 24.38 a | |||
| STDEV | 7.9 | 5.13 | |||
| Code | Closest Match | NCBI Accession NO. | Identity (%) |
|---|---|---|---|
| TDC029 | Lasiodiplodia theobromae | MK369927.1 | 100.00 |
| TDC075 | Trichoderma asperellum | MF061791.1 | 99.79 |
| TDC037 | Ceratobasidium sp. | KP089995.1 | 99.83 |
| TDC241 | Ceratobasidium sp. | KY965395.1 | 99.66 |
| TDC474 | Ceratobasidium sp. | KT265715.1 | 86.00 |
Publisher’s Note: MDPI stays neutral with regard to jurisdictional claims in published maps and institutional affiliations. |
© 2021 by the authors. Licensee MDPI, Basel, Switzerland. This article is an open access article distributed under the terms and conditions of the Creative Commons Attribution (CC BY) license (http://creativecommons.org/licenses/by/4.0/).
Share and Cite
Catambacan, D.G.; Cumagun, C.J.R. Weed-Associated Fungal Endophytes as Biocontrol Agents of Fusarium oxysporum f. sp. cubense TR4 in Cavendish Banana. J. Fungi 2021, 7, 224. https://doi.org/10.3390/jof7030224
Catambacan DG, Cumagun CJR. Weed-Associated Fungal Endophytes as Biocontrol Agents of Fusarium oxysporum f. sp. cubense TR4 in Cavendish Banana. Journal of Fungi. 2021; 7(3):224. https://doi.org/10.3390/jof7030224
Chicago/Turabian StyleCatambacan, Dennice G., and Christian Joseph R. Cumagun. 2021. "Weed-Associated Fungal Endophytes as Biocontrol Agents of Fusarium oxysporum f. sp. cubense TR4 in Cavendish Banana" Journal of Fungi 7, no. 3: 224. https://doi.org/10.3390/jof7030224
APA StyleCatambacan, D. G., & Cumagun, C. J. R. (2021). Weed-Associated Fungal Endophytes as Biocontrol Agents of Fusarium oxysporum f. sp. cubense TR4 in Cavendish Banana. Journal of Fungi, 7(3), 224. https://doi.org/10.3390/jof7030224

